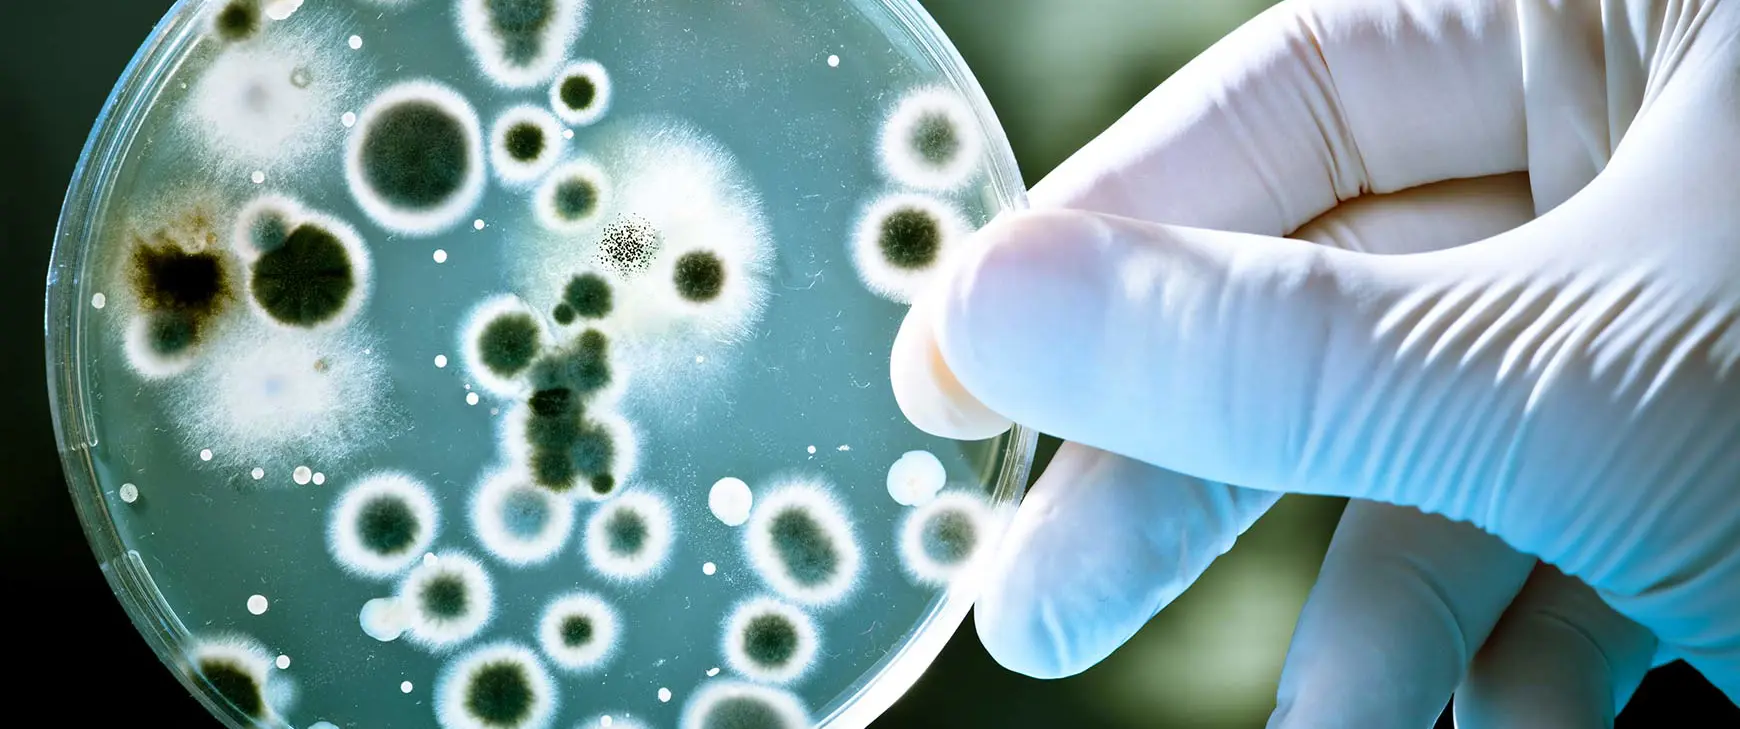

Im Kampf gegen Antibiotika-Resistenzen.
Weltweit sterben nach Angaben der WHO ca. 700'000 Personen jährlich an Infektionen gegen die keine Antibiotika mehr helfen. Also an den Folgen von Antibiotika-Resistenzen. Was Antibiotika Resistenzen sind und was DU dagegen tun kannst, erfährst du in diesem Blogbeitrag.
12. Februar 2020
Antibiotika bekämpfen Bakterien. Das wissen wir. Entweder sie töten die Bakterien oder sie hemmen deren Vermehrung oder deren Wachstum. Wir wissen aber auch, dass die Bakterien die Fähigkeit haben der Wirkung von Antibiotika zu widerstehen, sodass die Behandlung einer Infektion erschwert, verlängert oder im schlimmsten Fall sogar verunmöglicht wird. Doch weshalb entstehen Antibiotika Resistenzen? Vor allem weil Antibiotika nicht richtig eingesetzt werden. Entweder werden sie zu häufig, zu kurz oder zu niedrig dosiert angewendet oder sie werden gegen Viren eingesetzt und dass obwohl Antibiotika gegen Viren wirkungslos sind.
Jeder von uns kann dieser Problematik entgegenwirken. Allem voran heisst es Infektionen so gut wie möglich zu vermeiden oder aber auch sich durch den richtigen Umgang mit Antibiotika zu schützen. Deshalb gilt:
- Wasche regelmässig und gründlich deine Hände.
- Werfe nach dem Nasenputzen das Einmaltaschentuch sofort weg.
- Huste in deinen Ärmel und nicht in deine Hände.
- Wasche Obst und Gemüse, das roh gegessen wird, sehr gründlich.
- Lüfte mehrmals am Tag für einige Minuten.
- Wasche dein Geschirr und deine Wäsche regelmässig bei höheren Temperaturen.
- Nimm das vom Arzt verschriebene Antibiotikum so ein wie es dir verordnet wurde und lass keine Einnahme aus.
- Entsorge das Antibiotikum nie über die Toilette, nie über das Waschbecken und nie im Haushaltsmüll. Bringe die angebrochene Packung dorthin zurück wo du sie erhalten hast.
Im nächsten Blog stellen wir dir zwei Pflanzen vor, die gegen Bakterien wirken, ohne dass sie Resistenzen bilden: Kapuzinerkresse und Meerrettich. Eine gute Therapieoption im Kampf gegen die Antibiotikaresistenzen.
Themen
Filtern Sie die Blogbeiträge nach Themen, indem Sie auf die Tags klicken.